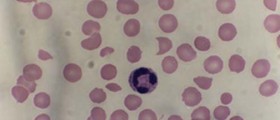

Common misconception
Unfortunately, there isquite a number of people today who are not familiar at all with the differencesand the characteristics of either serum or plasma. When it comes to theformer, important to mention is that this is a form of plasma but deprived ofclotting factors. On the other hand, the latter represents our blood’s liquidcomponent. Both of these terms are employed in relation to blood and bloodrelated actions. But in order to understand either of the two, a person mustfirst and foremost get as informed as possible about blood, its functions and structure, extensively.
When it comes toblood, what many might not be familiar with is that, roughly, as much as 8%of the entire body weight is taken up by blood. As far as its most importantfunctions are concerned, it is known that by way of blood, oxygen getstransferred to the body cells, as well as those most essential nutrients suchas the glucose, fatty and amino acids. Another highly important function of theblood is the elimination of unwanted toxic products like urea, lactic acid andcarbon dioxide from the above mentioned cells, as well as bodily tissues. In addition,blood is in charge of the responses of our immune system, clotting, and bodytemperature regulation among other things.
Important distinction
Since both serum andplasma are important constituents of the blood, they are employed quite oftenfor the purpose of performing blood tests and other related actions. Important tomention is that the property of the blood to perform those most importantbodily functions rests on plasma itself, proteins, blood cells, glucose andhormones primarily.
Serum represents a form of plasma,with the difference that it does not contain fibrinogen (protein liable forblood coagulation) and the rest of the clotting factors. It is comprised ofnon-clotting proteins, nutrients, glucose, hormones, electrolytes, antigens andantibodies.Plasma represents the medium ofblood itself, to which blood cells are suspended.When it comes to thelatter, it needs to be emphasized that it accounts to more than half of theblood’s volume – 90% of this being comprised of water and 10% of blood cells,nutrients etc. Given the fact that plasma takes up approximately 55% of blood,serum volume is present far less. When it comes to medicinalemployment, serum is used for the purpose of blood type checking anddetermination, as well as for diagnosing various illnesses. Plasma fulfillsthe role of a supplement, adding up to blood and compensating for the missingblood components in the person in question.

Your thoughts on this
Loading...